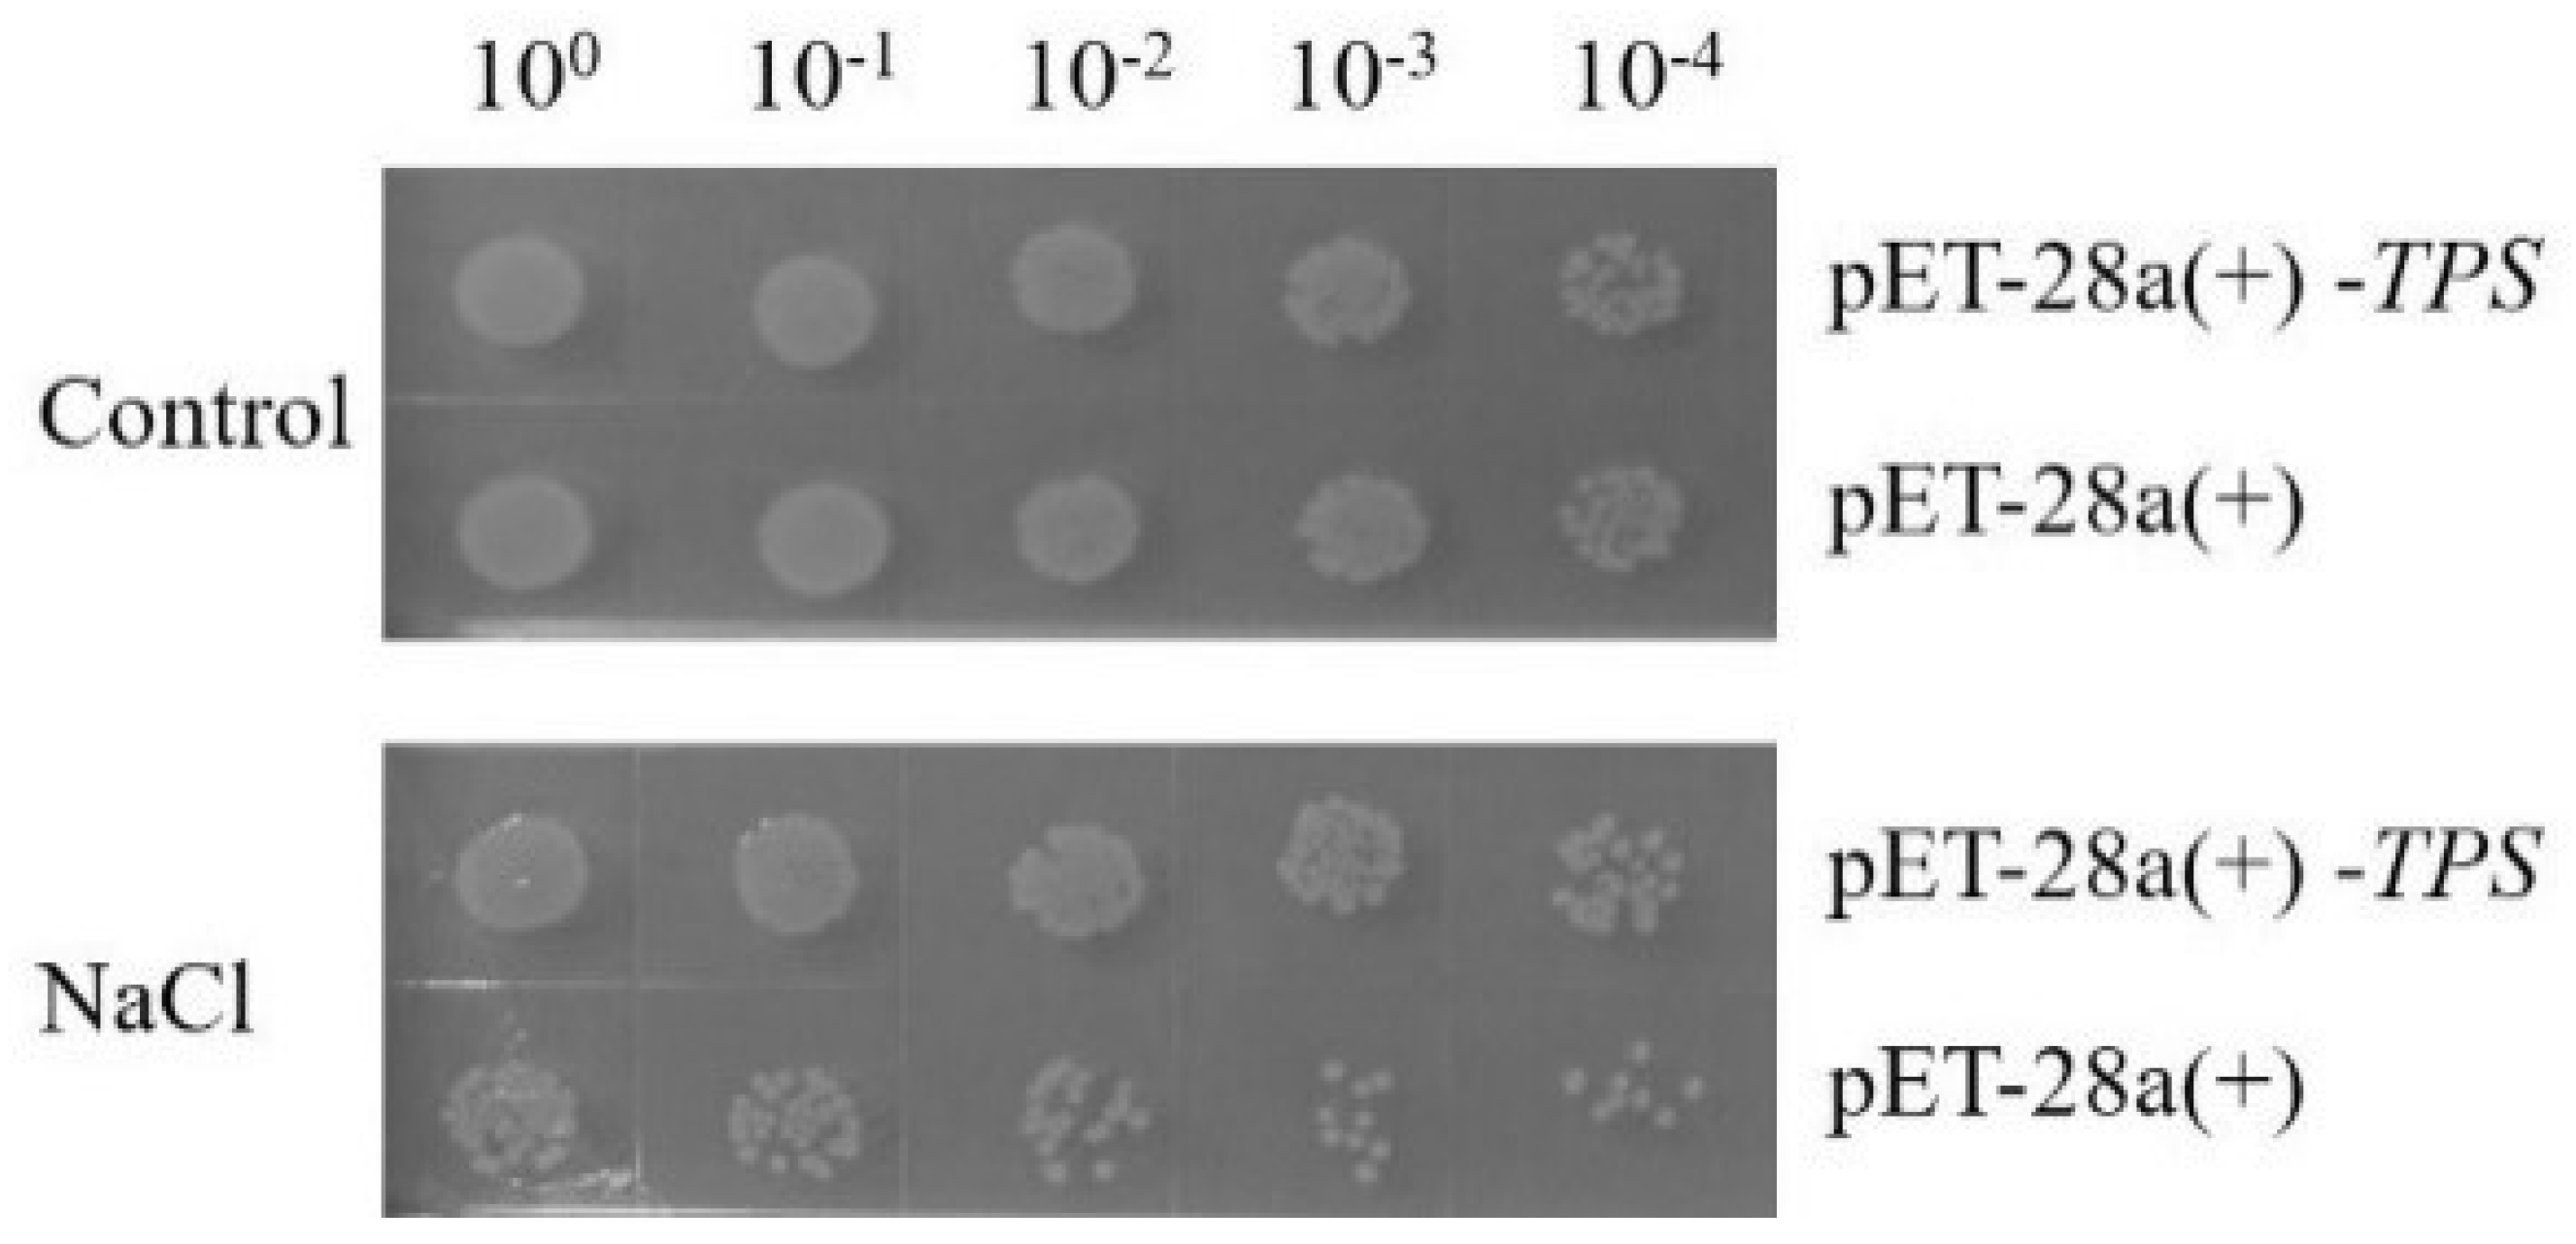
Molecules 28 05139 g003 Molecules 28 05139 g003

Molecular and Functional Analysis of Trehalose-6-Phosphate Synthase Genes Enhancing Salt Tolerance in Anoectochilus roxburghii (Wall.) Lindl.
Abstract
1. Introduction
2. Results
2.1. Open Reading Frame and Putative Proteins
2.2. Multiple Sequence Alignment and Phylogenetic Analysis
2.3. Overexpression of TPS Gene
2.4. Relative Expression Level under Induction
2.5. G6P and T6P Accumulation under Inducion
2.6. Glycometabolism and Kinsenoside Accumulation under Induction
3. Discussion
4. Materials and Methods
4.1. Sample Preparation
4.2. Cloning of the TPS Gene
4.3. Bioinformatic Analysis
4.4. Vector Construction
4.5. Protokaryotic Expression
4.6. RT-qPCR
4.7. G6P, T6P, and Glycometabolism Quantification
4.8. Kinsenoside Measurement
5. Conclusions
Supplementary Materials
Author Contributions
Funding
Informed Consent Statement
Data Availability Statement
Conflicts of Interest
References
- Lang, K.Y.; Chen, X.Q.; Luo, Y.B.; Zhu, G.H. Angiospermae. In Flora of China (Volume XVII); Editorial Board of Flora of China, Ed.; Science Press Beijing: Beijing, China, 1999; pp. 220–227. [Google Scholar]
- Shyur, L.F.; Chen, C.H.; Lo, C.P.; Wang, S.Y.; Kang, P.L.; Sun, S.J.; Chang, C.A.; Tzeng, C.M.; Yang, N.S. Induction of Apoptosis in MCF-7 Human Breast Cancer Cells by Phytochemicals from Anoectochilus formosanus. J. Biomed. Sci. 2004, 11, 928–939. [Google Scholar] [CrossRef] [PubMed]
- Yang, L.C.; Hsieh, C.C.; Lu, T.J.; Lin, W.C. Structurally characterized arabinogalactan from Anoectochilus formosanus as an immuno-modulator against CT26 colon cancer in BALB/c mice. Phytomedicine 2014, 21, 647–655. [Google Scholar] [CrossRef]
- Yu, X.; Lin, S.; Zhang, J.; Huang, L.; Yan, H.; Li, S. Purification of polysaccharide from artificially cultivated Anoectochilus roxburghii(wall.) Lindl. by high-speed counter current chromatography and its antitumor activity. J. Sep. Sci. 2017, 40, 4338–4346. [Google Scholar] [CrossRef] [PubMed]
- Du, X.M.; Sun, N.Y.; Irino, N.; Shoyama, Y. Glycosidic constituents from in vitro Anoectochilus formosanus. Chem. Pharm. Bull. 2000, 48, 1803–1804. [Google Scholar] [CrossRef] [PubMed]
- Shiau, Y.J.; Sagare, A.P.; Chen, U.C.; Yang, S.R.; Tsay, H.S. Conservation of Anoectochilus formosanus Hayata by artificial cross-pollination and in vitro culture of seeds. Bot. Bull. Acad. Sin. 2002, 43, 123–130. [Google Scholar]
- Zhang, J.G.; Liu, Q.; Liu, Z.L.; Li, L.; Yi, L.T. Antihyperglycemic activity of Anoectochilus roxburghii polysaccharose in diabetic mice induced by high-fat diet and streptozotocin. J. Ethnopharmacol. 2015, 164, 180–185. [Google Scholar] [CrossRef]
- Dai, Y.J.; Shao, M.M.; Hannaway, D.; Wang, L.L.; Liang, J.P.; Hu, L.N.; Lu, H.F. Effect of Thrips tabaci on anatomical features, photosynthetic characteristics and chlorophyll fluorescence of Hypericum sampsonii leaves. Crop Prot. 2009, 28, 327–332. [Google Scholar] [CrossRef]
- Elbein, A.D. The metabolism of α, α–trehalose. Adv. Carbohydr. Chem. Biochem. 1974, 30, 227–256. [Google Scholar]
- Zang, B.; Li, H.; Li, W.; Deng, X.W.; Wang, X. Analysis of trehalose-6-phosphate synthase (TPS) gene family suggests the formation of TPS complexes in rice. Plant. Mol. Biol. 2011, 76, 507–522. [Google Scholar] [CrossRef]
- Vogel, G.; Fienhn, O.; Louis, J.R.B.; Thomas, B.; Andres, W.; Aeschbacher, R.A.; Astrid, W. Trehalose metabolism in Arabidopsis: Occurrence of trehalose and molecul cloning and characterization of trehalose-6-phosphate synthase homologues. J. Exp. Bot. 2001, 52, 1817–1826. [Google Scholar] [CrossRef]
- Drennan, P.M.; Smith, M.T.; Goldsworthy, D.; Van Staden, J. The occurrence of trehalose in the leaves of the desiccation–tolerant angiosperm Myrothamnus flabellifolius Welw. J. Plant Physiol. 1993, 142, 493–496. [Google Scholar] [CrossRef]
- Müller, J.; Boller, T.; Wiemken, A. Trehalose and trehalase in plants: Recent developments. Plant. Sci. 1995, 112, 1–9. [Google Scholar] [CrossRef]
- Jiang, W.; Fu, F.L.; Zhang, S.Z.; Wu, L.; Li, W.C. Cloning and characterization of functional trehalose-6-phosphate synthase gene in maize. J. Plant Biol. 2010, 53, 134–141. [Google Scholar] [CrossRef]
- Song, J.B.; Mao, H.Y.; Cheng, J.; Zhou, Y.; Chen, R.R.; Zeng, L.M.; Li, H.; Wang, Y.H. Identification of the trehalose-6-phosphate synthase gene family in Medicago truncatula and expression analysis under abiotic stresses. Gene 2021, 787, 145641. [Google Scholar] [CrossRef]
- Chary, S.N.; Hicks, G.R.; Choi, Y.G.; Carter, D.; Raikhel, N.V. Trehalose-6-phosphate synthase/phosphatase regulates cell shape and plant architecture in Arabidopsis. Plant Physiol. 2008, 146, 97–107. [Google Scholar] [CrossRef]
- Blázque, M.A.; Santos, E.; Flores, C.L.; Martínez-Zapater, J.M.; Salinas, J.; Gancedo, C. Isolation and molecular characterization of the Arabidopsis TPS1 gene, encoding trehalose-6-phosphate synthase. Plant. J. 1998, 13, 685–689. [Google Scholar] [CrossRef]
- Jiang, T.; Zhai, H.; Wang, F.B.; Zhou, H.N.; Si, Z.Z.; He, S.Z.; Liu, Q.C. Cloning and characterization of a salt tolerance-associated gene encoding trehalose-6-phosphate synthase in Sweetpotato. J. Integr. Agr. 2014, 13, 1651–1661. [Google Scholar] [CrossRef]
- Wang, P.L.; Lei, X.J.; Lü, J.X.; Gao, C.Q. Overexpression of the ThTPS gene enhanced salt and osmotic stress tolerance in Tamarix hispida. J. For. Res. 2020, 1, 299–308. [Google Scholar] [CrossRef]
- Wu, W.; Pang, Y.; Shen, G.A. Molecular Cloning, Characterization and Expression of a Novel Trehalose-6-phosphate Synthase Homologue from Ginkgo biloba. J. Biochem. Mol. Biol. 2006, 39, 158–166. [Google Scholar] [CrossRef] [PubMed]
- Ding, F.; Pang, L.; Li, Y.Y. Cloning and Expression Analysis of Trehalose-6-phosphate Synthase Gene (CsTPS) from Tea Plant (Camellia sinensis (L.) O. Kuntz). J. Agric. Biotec. 2012, 20, 1253–1261. [Google Scholar]
- Wang, X.L.; Du, Y.; Yu, D.Q. Trehalose phosphate synthase 5-dependent trehalose metabolism modulates basal defense responses in Arabidopsis thaliana FA. J. Integr. Plant Biol. 2019, 61, 509–527. [Google Scholar] [CrossRef]
- Schluepmann, H.; Pellny, T.; van Dijken, A. Trehalose 6-phosphate is indispensable for carbohydrate utilization and growth in Arabidopsis thaliana. Proc. Natl. Acad. Sci. USA 2003, 100, 6849–6854. [Google Scholar] [CrossRef] [PubMed]
- Kosar, F.; Akram, N.A.; Sadiq, M.; AI-Qurainy, F.; Ashraf, M. Trehalose: A key organic osmolyte effectively involved in plant abiotic stress tolerance. J. Plant Growth Regul. 2019, 38, 606–618. [Google Scholar] [CrossRef]
- Paul, M.J.; Watson, A.; Griffiths, C.A. Trehalose 6-phosphate signalling and impact on crop yield. Biochem. Soc. Trans. 2020, 48, 2127–2137. [Google Scholar] [CrossRef]
- Cabib, E.; Leloir, L.F. The biosynthesis of trehalose phosphate. J. Biol. Chem. 1958, 231, 259–275. [Google Scholar] [CrossRef] [PubMed]
- Goddijn, O.J.; Van Dun, K. Trehalose metabolism in plants. Trends. Plant Sci. 1999, 4, 315–319. [Google Scholar] [CrossRef]
- Gómez, L.D.; Gilday, A.; Feil, R.; Lunn, J.E.; Graham, I.A. AtTPS1-mediated trehalose 6-phosphate synthesis is essential for embryogenic and vegetative growth and responsiveness to ABA in germinating seeds and stomatal guard cells. Plant J. 2010, 64, 1–13. [Google Scholar] [CrossRef]
- Wingler, A.; Delatte, T.L.; O’Hara, L.E.; Primavesi, L.F.; Jhurreea, D.; Paul, M.J.; Schluepmann, H. Trehalose 6-phosphate is required for the onset of leaf senescence associated with high carbon availability. Plant Physiol. 2012, 158, 1241–1251. [Google Scholar] [CrossRef]
- Wahl, V.; Ponnu, J.; Schlereth, A.; Arrivault, S.; Langenecker, T.; Franke, A.; Feil, R.; Lunn, J.E.; Stitt, M.; Schmid, M. Regulation of flowering by trehalose-6-phosphate signaling in Arabidopsis thaliana. Science 2013, 339, 704–707. [Google Scholar] [CrossRef]
- Kumar, R.; Bishop, E.; Bridges, W.C.; Tharayil, N.; Sekhon, R.S. Sugar partitioning and source–sink interaction are key determinants of leaf senescence in maize. Plant. Cell Environ. 2019, 42, 2597–2611. [Google Scholar] [CrossRef]
- Zhao, M.L.; Ni, J.; Chen, M.S.; Xu, Z.F. Ectopic expression of jatropha curcas trehalose-6-phosphate phosphatase causes late-flowering and heterostylous phenotypes in Arabidopsis but not in Jatropha. Int. J. Mol. Sci. 2019, 20, 2165. [Google Scholar] [CrossRef]
- Yang, H.; Liu, Y.; Wang, C.; Zeng, Q. Molecular Evolution of trehalose-6-phosphate synthase (TPS) gene family in Populus Arabidopsis and rice. PLoS ONE 2012, 7, e42438. [Google Scholar] [CrossRef]
- Zhao, F.; Li, Q.; Weng, M.; Wang, X.; Guo, B.; Wang, L.; Wang, W.; Duan, D.; Wang, B. Cloning of TPS gene from eelgrass species Zostera marina and its functional identification by genetic transformation in rice. Gene 2013, 531, 205–211. [Google Scholar] [CrossRef]
- Avonce, N.; Leyman, B.; Mascorro-Gallardo, J.O.; Dijck, P.V.; Thevelein, J.M.; Iturriaga, G. The Arabidopsis trehalose-6-P synthase AtTPS1 gene is a regulator of glucose, abscisic acid, and stress signaling. Plant Physiol. 2004, 136, 3649–3659. [Google Scholar] [CrossRef]
- Lyu, J.I.; Min, S.R.; Lee, J.H.; Lim, Y.H.; Kim, J.K.; Bae, C.H.; Liu, J.R. Overexpression of a 6-phosphate synthase/phosphatase fusion gene enhances tolerance and photosynthesis during drought and salt stress without growth aberrations in tomato. Plant. Cell Tiss. Org. 2013, 112, 257–262. [Google Scholar] [CrossRef]
- He, S.; Tan, L.L.; Hu, Z.L.; Chen, G.P.; Wang, G.X.; Hu, T.Z. Molecular characterization and functional analysis by heterologous expression in E. coli under diverse abiotic stresses for OsLEA5, the atypical hydrophobic LEA protein from Oryza sativa L. Mol. Genet. Genom. 2012, 287, 39–54. [Google Scholar] [CrossRef]
- Udawat, P.; Mishra, A.; Jha, B. Heterologous expression of an uncharacterized uni-versal stress protein gene (SbUSP) from the extreme halophyte, Salicornia brachiata, which confers salt and osmotic tolerance to E. coli. Gene 2014, 536, 163–170. [Google Scholar] [CrossRef]
- Zhang, G.; Zhao, M.; Song, C.; Luo, A.; Bai, J.; Guo, S. Characterization of reference genes for quantitative real-time PCR analysis in various tissues of Anoectochilus roxburghii. Mol. Biol. Rep. 2012, 39, 5905–5912. [Google Scholar] [CrossRef] [PubMed]
- Livak, K.J.; Schmittgen, T.D. Relative gene expression data was analyzed using real-time quantitative PCR and the 2−ΔΔCT method. Methods 2001, 25, 402–408. [Google Scholar] [CrossRef]

Disclaimer/Publisher’s Note: The statements, opinions and data contained in all publications are solely those of the individual author(s) and contributor(s) and not of MDPI and/or the editor(s). MDPI and/or the editor(s) disclaim responsibility for any injury to people or property resulting from any ideas, methods, instructions or products referred to in the content. |
© 2023 by the authors. Licensee MDPI, Basel, Switzerland. This article is an open access article distributed under the terms and conditions of the Creative Commons Attribution (CC BY) license (https://creativecommons.org/licenses/by/4.0/).
Share and Cite
Yang, L.; Dai, L.; Zhang, H.; Sun, F.; Tang, X.; Feng, W.; Yu, H.; Zhang, J. Molecular and Functional Analysis of Trehalose-6-Phosphate Synthase Genes Enhancing Salt Tolerance in Anoectochilus roxburghii (Wall.) Lindl. Molecules 2023, 28, 5139. https://doi.org/10.3390/molecules28135139
Yang L, Dai L, Zhang H, Sun F, Tang X, Feng W, Yu H, Zhang J. Molecular and Functional Analysis of Trehalose-6-Phosphate Synthase Genes Enhancing Salt Tolerance in Anoectochilus roxburghii (Wall.) Lindl. Molecules. 2023; 28(13):5139. https://doi.org/10.3390/molecules28135139
Chicago/Turabian StyleYang, Lin, Luwei Dai, Hangying Zhang, Fuai Sun, Xuchong Tang, Wenqi Feng, Haoqiang Yu, and Juncheng Zhang. 2023. "Molecular and Functional Analysis of Trehalose-6-Phosphate Synthase Genes Enhancing Salt Tolerance in Anoectochilus roxburghii (Wall.) Lindl." Molecules 28, no. 13: 5139. https://doi.org/10.3390/molecules28135139
APA StyleYang, L., Dai, L., Zhang, H., Sun, F., Tang, X., Feng, W., Yu, H., & Zhang, J. (2023). Molecular and Functional Analysis of Trehalose-6-Phosphate Synthase Genes Enhancing Salt Tolerance in Anoectochilus roxburghii (Wall.) Lindl. Molecules, 28(13), 5139. https://doi.org/10.3390/molecules28135139

